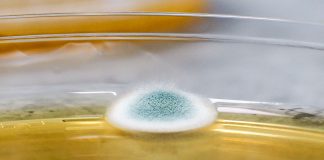
TESTY MIKROBIOLOGICKÉ STABILITY VÍNA

Tiskové zprávy
Víno&Styl 71
Není nic hezčího, než když začne hrát příroda všemi barvami. Ale taky je to pořádný frmol. Stačí, aby se objevily první žluté listy, a pro...
Tipy na vinařské akce – 51 – 52. týden
Vánoce, vánoce ze všech stran vánoce. Tip pro ty, co se nechtějí stresovat: Nemáte všechny dárky? Dejte si dvě deci!! Nemáte stromeček? Dejte si...
Od špuntu k botě
Co mají společného skleněný špunt Vinolok a luxusní dámské střevíčky od legendárního návrháře Manola Blahnika? Zkuste hádat. A hlavně se můžete kochat. Obojí je...
Patrik má opět zelenou. Irský průvod v Praze i dalších městech
Zelený průvod již podruhé rozzáří Prahu hráškově zelenou barvou a oslavy svatého Patrika se chystají i v dalších městech. Populární svátek překonal hranice Irska a...
Tipy na vinařské akce – 18. týden
Vinaři ze spolku Víno z Velkých Pavlovic otevřou své sklepy od 30. dubna do konce září. Během akce Letní otevřené sklepy budou pro veřejnost...
Tipy na vinařské akce – 7. týden
Svatý Valentýn klepe na dveře. Růžová vína, sekty a čokolády mizí z pultů obchodů a zamilovaní se houfují na romantických místech. Slavit svátek bez...
HRAD LITOMĚŘICE představí jedinečná díla slovenského ateliéru na Drotárskej. Vinařství Hutár partnerem výstavy...
Spojovat umění s vínem, vinařskou krajinou oblasti Litoměřice i historickými místy, kde se již tradičně snoubí tyto zdroje potěšení dohromady, je ambicí litoměřického vinařství...
Prague Wine Week 2018
V týdnu od 22. do 28. ledna 2018 se Praha stane dějištěm jubilejního desátého ročníku festivalu vína Prague Wine Week 2018, kterého je náš...
Česko má svou národní sommelierku. Klára Kollárová se stala hlavní zástupkyní českých a moravských...
Nová pozice národního sommeliera vyžaduje absolutní profesionalitu, v důsledku jedinečných půdních a klimatických podmínek je práce s českými a moravskými víny velmi náročnou a...
Featured
Most Popular
TESTY MIKROBIOLOGICKÉ STABILITY VÍNA
Společnost BS vinařské potřeby před nedávnem otevřela zcela novou část své BS laboratoře ve Velkých Bílovicích. Ta se zabývá testováním mikrobiologické stability vína. Tento...
Latest reviews
Víno&Styl 73
VÍNO, víno, víno a ještě jednou...VÍNO.
Prý je v něm pravda. Ale bacha, dnes není jedno, jak ji člověk říká.
Psát v oboru, kde zacházení s jazykem neznamená...
TŘIKRÁT NA ZDRAVÍ! A NA PATRIKA
Hromadné oslavy se nekonají, takže na již tradiční průvod sv. Patrika můžeme zapomenout, ale ZELENÝ DEN a s ním veselou oslavu jara přece neodpískáme. 17....
Třináct zlatých, třináct stříbrných. Naše vína opět bodovala na prestižní soutěži...
Moravská a česká vína zaznamenala další mezinárodní úspěch. Na 32. ročníku prestižní mezinárodní soutěže Concours Mondial de Bruxelles získala v kategorii červených a bílých...